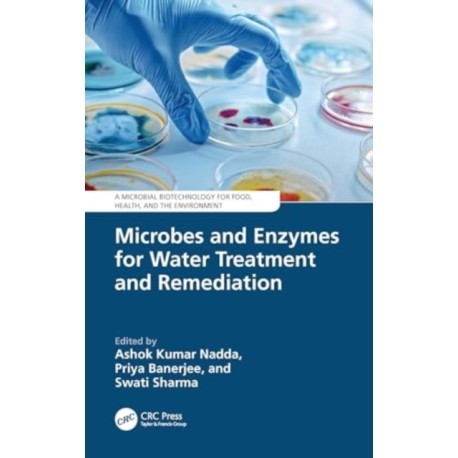
Microbes and Enzymes for Water Treatment and Remediation

Kurv
Vare
varer
(tom)
Ingen varer
Fastlægges senere
Forsendelse
0,- kr
I alt
Microbes and Enzymes for Water Treatment and Remediation
(Bog, Hardback, Engelsk)
Forlag:
Taylor & Francis Ltd
- Type: Bog
- Format: Hardback
-
Sprog:
Engelsk

- ISBN-13: 9781032850757
- Se flere detaljer ▼
Beskrivelse
The book provides up-to-date insights into the potential of microbial and enzyme-based processes for wastewater treatment, addressing challenges and limitations while offering alternative methods for effluent treatment and water reclamation.
Læsernes anmeldelser (0)
Alle detaljer
| Forlag | Taylor & Francis Ltd |
| Type | Bog |
| Format | Hardback |
| Sprog | Engelsk |
| Udgivelsesdato | 01-10-2024 |
| Første udgivelsesår | 2024 |
| Serie | Microbial Biotechnology for Food, Health, and the Environment |
| Illustrationer | 22 Tables, black and white; 42 Line drawings, black and white; 1 Halftones, black and white; 43 Illustrations, black and white |
| Fagredaktør | Ashok Kumar (Jaypee University of Information Technology Nadda, Priya Banerjee, Swati (University of California Sharma |
| Originalsprog | United Kingdom |
| Sideantal | 214 |
| Indbinding | Hardback |
| Forlag | Taylor & Francis Ltd |
| Sideoplysninger | 214 pages, 22 Tables, black and white; 42 Line drawings, black and white; 1 Halftones, black and whi |
| Mål | 234 x 156 |
| ISBN-13 / EAN-13 | 9781032850757 |

